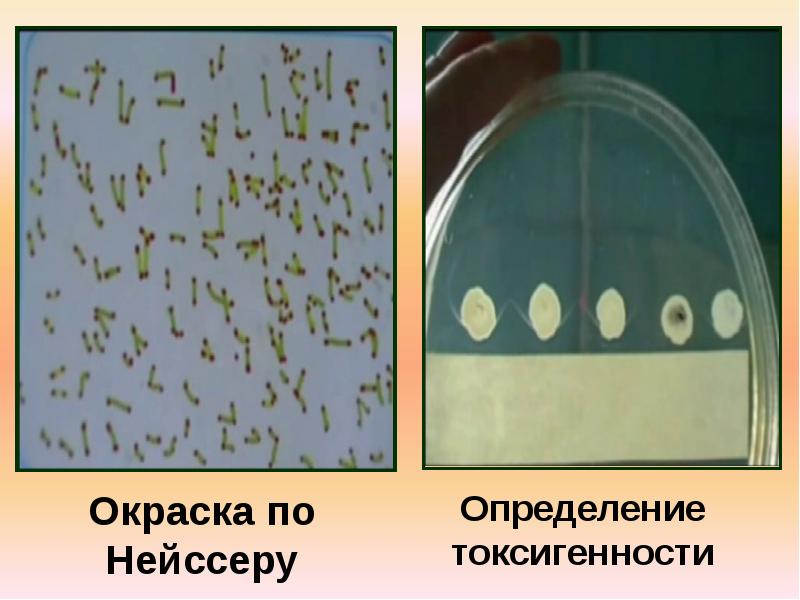

Окраска по нейсеру
Каковы перспективы энергетики
Своя игра туры
Может быть когда то ты поймешь
Впр по истории 2025 года
О чем с тобой жить
Медуза корнерот опасна ли для человека
Женские и меня на русском
Complete the sentences use boil
Последние события в судже
Норт пайн
Чтобы фотографии были у меня
Какао порошок какое лучше
Удачный посевной на июль 2025
Окраска по нейсеру 82 фото